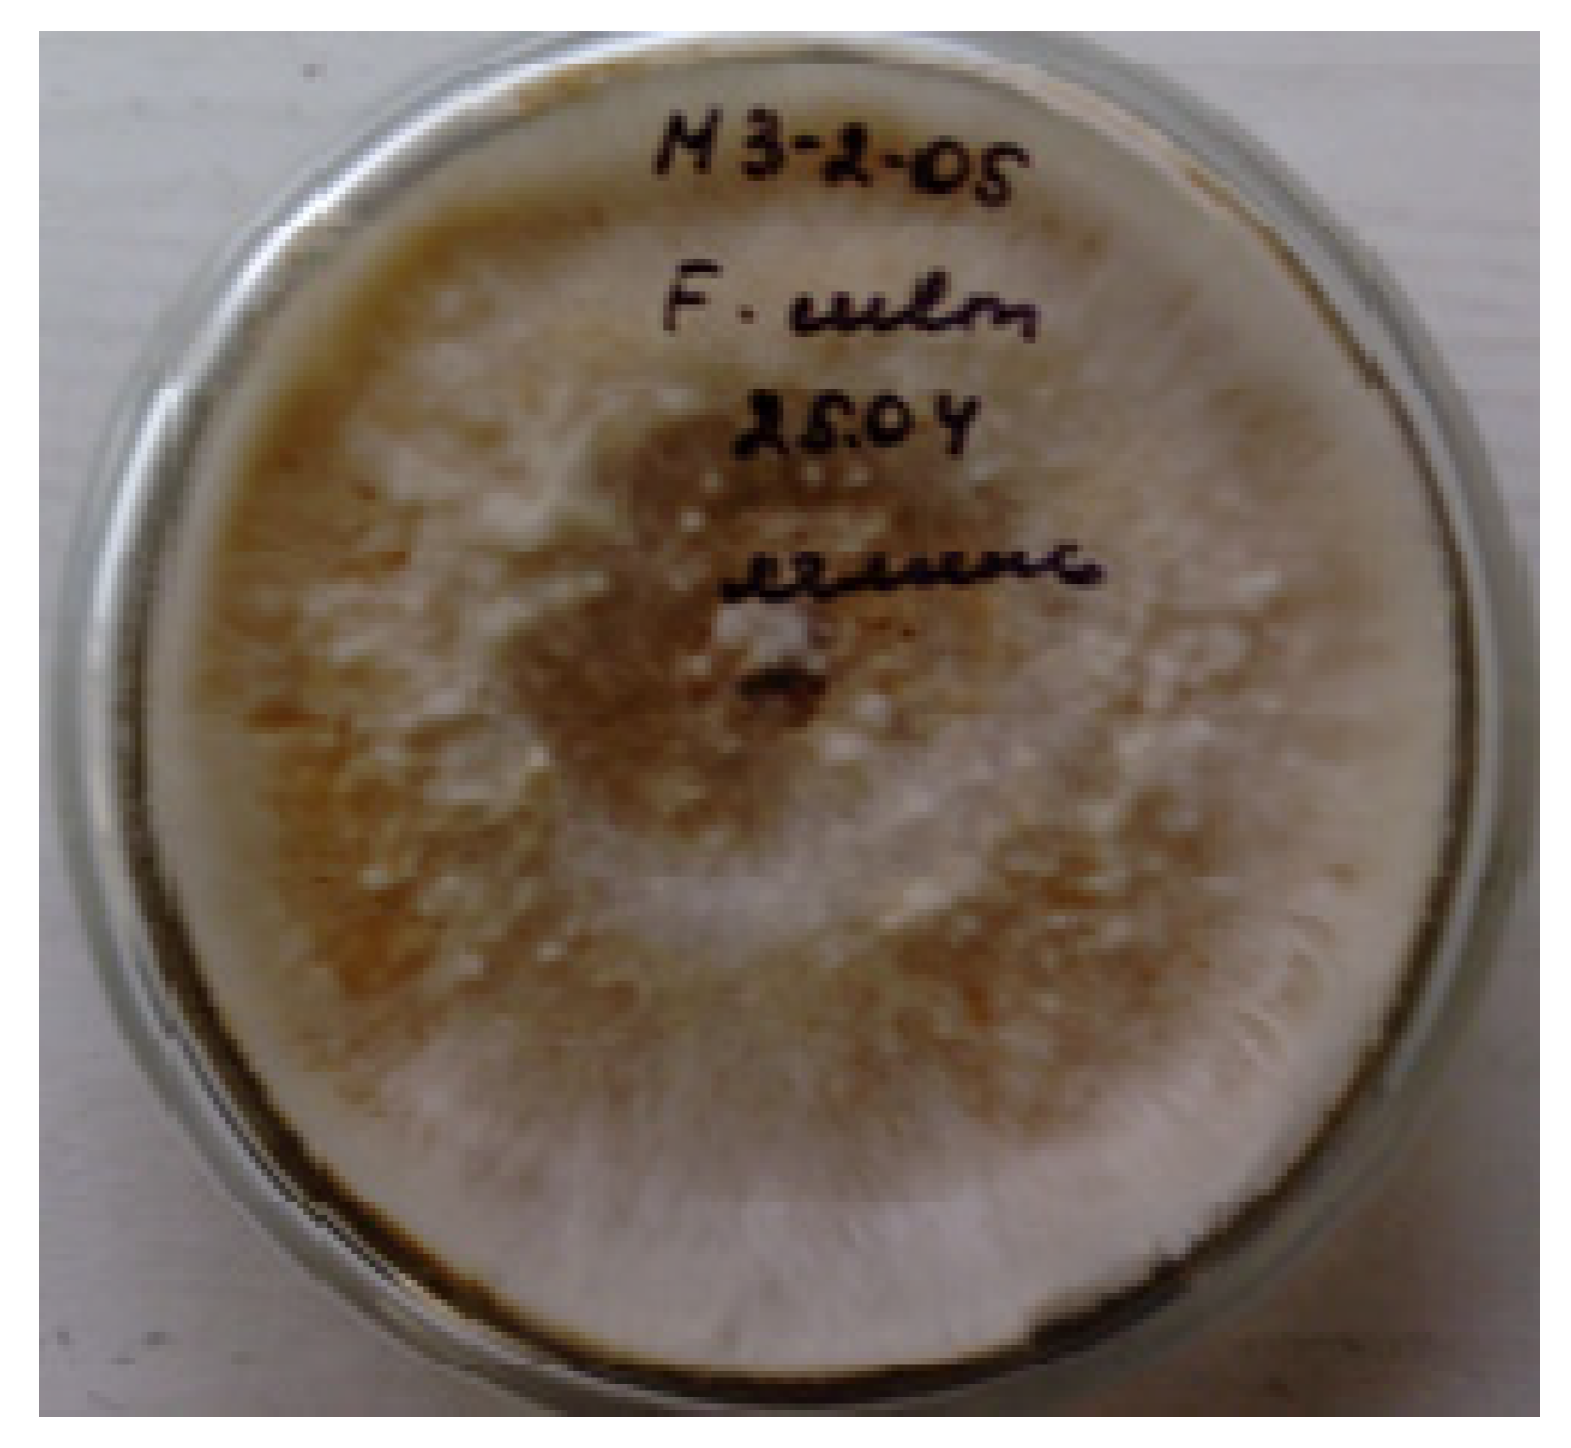
Pathogens 12 01051 g001

Naked Oat and Fusarium culmorum (W.G.Sm.) Sacc. Responses to Growth Regulator Effects
Abstract
:1. Introduction
2. Materials and Methods
- First, 1 mL of ammonium molybdate and 200 μL of the sample extract were added to 1 mL of a substrate, and the adsorption of the mixture (A1) was determined.
- Next, 1 mL of the substrate was supplemented with 1 mL of ammonium molybdate and 200 μL of 60 mM K-Na-phosphate buffer, and the adsorption of the mixture (A2) was determined.
- Finally, 1.2 mL of 60 mM K-Na-phosphate buffer was supplemented with 1 mL of ammonium molybdate followed by the adsorption measurement (A3).
3. Results
3.1. Evaluation of the Yield and 1000 Kernels Weight after Artificial Fusarium Infection and Treatment with Growth Regulators
3.2. Proline Content Determination
3.3. Determination of the Low-Molecular Fructose Content
3.4. Determination of the Content of Phenolic Compounds and Flavonoids
3.5. Antioxidant Activity Determination
3.6. Activity of Antioxidant Defense Enzymes
3.7. Biochemical Composition of Grain
4. Discussion
5. Conclusions
Author Contributions
Funding
Institutional Review Board Statement
Informed Consent Statement
Data Availability Statement
Conflicts of Interest
References
- Das, K.; Roychoudhury, A. Reactive oxygen species (ROS) and response of antioxidants as ROS-scavengers during environmental stress in plants. Front. Environ. Sci. 2014, 2, 53. [Google Scholar] [CrossRef]
- Yang, T.; Poovaiah, B.W. Hydrogen peroxide homeostasis: Activation of plant catalase by calcium/calmodulin. Proc. Natl. Acad. Sci. USA 2002, 99, 4097–4102. [Google Scholar] [CrossRef]
- Madadkhah, E.; Lotfi, M.; Nabipour, A.; Rahmanpour, S.; Banihashemi, Z.; Shoorooei, M. Enzymatic activities in roots of melon genotypes infected with Fusarium oxysporum f. sp. melonis race 1. Sci. Hortic. 2012, 135, 171–176. [Google Scholar] [CrossRef]
- Wang, W.; Xia, M.X.; Chen, J.; Yuan, R.; Deng, F.N.; Shen, F. Gene expression characteristics and regulation mechanisms of superoxide dismutase and its physiological roles in plants under stress. Biochemistry 2016, 81, 465–480. [Google Scholar] [CrossRef] [PubMed]
- Gechev, T.S.; Hille, J. Hydrogen peroxide as a signal controlling plant programmed cell death. J. Cell Biol. 2005, 168, 17–20. [Google Scholar] [CrossRef]
- Dumanović, J.; Nepovimova, E.; Natić, M.; Kuča, K.; Jaćević, V. The Significance of Reactive Oxygen Species and Antioxidant Defense System in Plants: A Concise Overview. Front. Plant Sci. 2021, 11, 552969. [Google Scholar] [CrossRef] [PubMed]
- Torres, M.A.; Jones, J.D.; Dangl, J.L. Reactive oxygen species signaling in response to pathogens. Plant Physiol. 2006, 141, 373–378. [Google Scholar] [CrossRef] [PubMed]
- Levine, A.; Tenhaken, R.; Dixon, R.; Lamb, C. H2O2 from the oxidative burst orchestrates the plant hypersensitive disease resistance response. Cell 1994, 79, 583–593. [Google Scholar] [CrossRef]
- Hammerschmidt, R. Induced disease resistance: How do induced plants stop pathogens? Physiol. Mol. Plant Pathol. 1999, 55, 77–84. [Google Scholar] [CrossRef]
- Simon, M.; Hilker, M. Herbivores and pathogens on willow: Do they affect each other? Agric. For. Entomol. 2003, 5, 275–284. [Google Scholar] [CrossRef]
- Stout, M.J.; Thaler, J.S.; Thomma, B.P.H.J. Plant-mediated interactions between pathogenic microorganisms and herbivorous arthropods. Annu. Rev. Entomol. 2006, 51, 663–689. [Google Scholar] [CrossRef] [PubMed]
- Lehmann, S.; Serrano, M.; L’Haridon, F.; Tjamos, S.E.; Metraux, J.-P. Reactive oxygen species and plant resistance to fungal pathogens. Phytochemistry 2015, 112, 54–62. [Google Scholar] [CrossRef] [PubMed]
- Lanoue, A.; Burlat, V.; Henkes, G.J.; Koch, I.; Schurr, U.; Röse, U.S. De novo biosynthesis of defense root exudates in response to Fusarium attack in barley. New Phytol. 2010, 185, 577–588. [Google Scholar] [CrossRef] [PubMed]
- Ponts, N.; Pinson-Gadais, L.; Boutigny, A.L.; Barreau, C.; Richard-Forget, F. Cinnamic-derived acids significantly affect Fusarium graminearum growth and in vitro synthesis of type B trichothecenes. Phytopathology 2011, 101, 929–934. [Google Scholar] [CrossRef] [PubMed]
- Shalaby, S.; Horwitz, B.A. Plant phenolic compounds and oxidative stress: Integrated signals in fungal–plant interactions. Curr. Genet. 2014, 61, 347–357. [Google Scholar] [CrossRef]
- Aggarwal, M.; Sharma, S.; Kaur, N.; Pathania, D.; Bhandhari, K.; Kaushal, N.; Kaur, R.; Singh, K.; Srivastava, A.; Nayyar, H. Exogenous proline application reduces phytotoxic effects of selenium by minimising oxidative stress and improves growth in bean (Phaseolus vulgaris L.) seedlings. Biol. Trace Elem. Res. 2011, 140, 354–367. [Google Scholar] [CrossRef]
- Ben Ahmed, C.; Ben Rouina, B.; Sensoy, S.; Boukhriss, M.; Ben Abdullah, F. Exogenous proline effects on photosynthetic performance and antioxidant defense system of young olive tree. J. Agric. Food Chem. 2010, 58, 4216–4222. [Google Scholar] [CrossRef]
- Herbers, K.; Takahata, Y.; Melzer, M.; Mock, H.-P.; Hajirezaei, M.; Sonnewald, U. Regulation of carbohydrate partitioning during the interaction of potato virus Y with tobacco. Mol. Plant Pathol. 2000, 1, 51–59. [Google Scholar] [CrossRef]
- Pociecha, E.; Płażek, A.; Janowiak, F.; Dubert, F.; Kolasińska, I.; Irla, M. Factors contributing toenhancedpinksnowmould resistance of winter rye (Secale cereale L.)–Pivotal role of crowns. Physiol. Mol. Plant Pathol. 2013, 81, 54–63. [Google Scholar] [CrossRef]
- Streuter, N.; Moerschbacher, B.; Fischer, Y.; Noll, U.; Reisener, H. Fructose-2,6-Bisphosphate in Wheat Leaves Infected with Stem Rust. J. Plant Physiol. 1989, 134, 254–257. [Google Scholar] [CrossRef]
- Gaudet, D.A.; Laroche, A.; Yoshida, M. Low temperature-wheat-fungal interactions: A carbohydrate connection. Physiol. Plant. 1999, 106, 437–444. [Google Scholar] [CrossRef]
- Eveland, A.; Jackson, D.P. Sugars, signalling, and plant development. J. Exp. Bot. 2012, 63, 3367–3377. [Google Scholar] [CrossRef] [PubMed]
- Marshall, A.; Cowan, S.; Edwards, S.; Griffiths, I.; Howarth, C.; Langdon, T.; White, E. Crops That Feed the World 9. Oats—A Cereal Crop for Human and Livestock Feed with Industrial Applications. Food Secur. 2013, 5, 13–33. [Google Scholar] [CrossRef]
- Parry, D.W.; Jenkinson, P.; McLeod, L. Fusarium Ear Blight (Scab) in Small Grain Cereals—A Review. Plant Pathol. 1995, 44, 207–238. [Google Scholar] [CrossRef]
- Havrlentová, M.; Šliková, S.; Gregusová, V.; Kovácsová, B.; Lančaričová, A.; Nemeček, P.; Hendrichová, J.; Hozlár, P. The Influence of Artificial Fusarium Infection on Oat Grain Quality. Microorganisms 2021, 9, 2108. [Google Scholar] [CrossRef]
- Steenackers, W.; El Houari, I.; Baekelandt, A.; Witvrouw, K.; Dhondt, S.; Leroux, O.; Vanholme, B. cis-Cinnamic acid is a natural plant growth-promoting compound. J. Exp. Bot. 2019, 70, 6293–6304. [Google Scholar] [CrossRef]
- Kefeli, V.I.; Utjcek, M.K. Phenolic substances and their possible role in plant growth regulation. In Proceedings of the 9th International Conference on Plant Growth Substances, Lausanne, Switzerland, 30 August–4 September 1976; Springer: Berlin/Heidelberg, Germany, 1977; pp. 181–189. [Google Scholar]
- Boronkov, M.G.; Gorbalinskiĭ, V.A.; D’iakov, V.M. Krezatsin—Novyĭ biostimuliator mikrobiologicheskogo sinteza [Crezacin--a new biostimulator of microbiological synthesis]. Dokl. Akad. Nauk 1999, 369, 831–832. [Google Scholar]
- Sardarova, I.I.; Kalashnikova, E.A.; Temirbekova, S.K.; Kirakosyan, R.N.; Glinushkin, A.P. Influence of growth regulators on phytopathogenic fungi of the genus Fusarium L. Agrar. Sci. 2019, 2, 107–109. [Google Scholar] [CrossRef]
- Bilay, V.I.; Kurbatskaya, Z.A. Determinant of Toxin-Forming Micromycetes; Naukova Dumka: Kyiv, Ukraine, 1990; 236p. [Google Scholar]
- Murashige, T.A.; Skoog, F. Revised Medium for Rapid Growth and Bio Assays with Tobacco Tissue Cultures. Physiol. Plantarum. 1962, 15, 473–497. [Google Scholar] [CrossRef]
- Šrobárová, A.; Pavlová, A. Toxicity of Secondary Metabolites of the Fungus F. culmorum in Relation to Resistance of Winter Wheat Cultivars. Cereal Res. Commun. 2001, 29, 101–108. [Google Scholar] [CrossRef]
- Ainsworth, E.A.; Gillespie, K.M. Estimation of total phenolic content and other oxidation substrates in plant tissues using Folin-Ciocalteu reagent. Nat. Protoc. 2007, 2, 875–877. [Google Scholar] [CrossRef] [PubMed]
- Horszwald, A.; Andlauer, W. Characterisation of bioactive compounds in berry juices by traditional photometric and modern microplate methods. J. Berry Res. 2011, 1, 189–199. [Google Scholar] [CrossRef]
- Oyaizu, M. Studies on Products of Browning Reactions: Antioxidative Activities of Product of Browning Reaction Prepared from Glucosamine. Jpn. J. Nutr. 1986, 44, 307–315. [Google Scholar] [CrossRef]
- Goth, L. A simple method for determination of serum catalase activity and revision of reference range. Clin. Chim. Acta 1991, 196, 143–152. [Google Scholar] [CrossRef]
- Kruger, N.J. The Bradford method for protein quantitation. In The Protein Protocols Handbook; Humana Press: Totowa, NJ, USA, 2009; pp. 17–24. [Google Scholar]
- Nakano, Y.; Asada, K. Hydrogen Peroxide Is Scavenged by Ascorbate specific Peroxidase in Spinach Chloroplasts. Plant Cell Physiol. 1981, 22, 867–880. [Google Scholar]
- Popov, T.; Neikovskaya, L. Method for determining blood peroxidase activity. Hyg. Sanit. 1971, 10, 89–91. [Google Scholar]
- Ermakov, A.I.; Arasimovich, V.V.; Smirnova-Ikonnikova, M.I.; Yarosh, N.P.; Lukovnikova, G.A. Methods of Biochemical Research of Plants; Nauka: Moscow, Russia, 1987; 430p. [Google Scholar]
- GOST 10846-91; Grain and Products of Its Processing. Protein Determination Method. IPK Publishing House of Standards: Moscow, Russia, 2001.
- GOST 29033-91; Grain and Products of Its Processing. Fat Determination Method. IPK Standards Publishing House: Moscow, Russia, 1992.
- Gilbert, J.; Tekauz, A.; Woods, S.M. Effect of storage on viability of fusarium head blight-affected spring wheat seed. Plant Dis. 1997, 81, 159–162. [Google Scholar] [CrossRef]
- Yli-Mattila, T. Ecology and evolution of toxigenic Fusarium species in cereals in northern Europe and Asia. J. Plant Pathol. 2010, 92, 7–18. [Google Scholar]
- Temirbekova, S.K.; Kalashnikova, E.A.; Sardarova, I.I.; Kirakosyan, R.N.; Kabashov, A.D. Effect of growth regulators on the development of fungi of the genus Fusarium spp. in organic (ecological) agriculture. Agrar. Sci. 2019, 1, 123–126. [Google Scholar] [CrossRef]
- Iwaniuk, P.; Lozowicka, B.; Kaczynski, P.; Konecki, R. Multifactorial wheat response under Fusarium culmorum, herbicidal, fungicidal and biostimulator treatments on the biochemical and mycotoxins status of wheat. J. Saudi Soc. Agric. Sci. 2021, 20, 443–453. [Google Scholar] [CrossRef]
- Chen, L.-Q.; Hou, B.-H.; Lalonde, S.; Takanaga, H.; Hartung, M.L.; Qu, X.-Q.; Guo, W.-J.; Kim, J.-G.; Underwood, W.; Chaudhuri, B.; et al. Sugar transporters for intercellular exchange and nutrition of pathogens. Nature 2010, 468, 527–532. [Google Scholar] [CrossRef] [PubMed]
- Jeandet, P.; Vannozzi, A.; Sobarzo-Sanchez, E.; Uddin, M.S.; Bru, R.; Martinez-Marquez, A.; Clément, C.; Cordelier, S.; Manayi, A.; Nabavi, S.F.; et al. Phytostilbenes as agrochemicals: Biosynthesis, bioactivity, metabolic engineering and biotechnology. Nat. Prod. Rep. 2021, 28, 1282–1329. [Google Scholar] [CrossRef] [PubMed]
- Morkunas, I.; Narożna, D.; Nowak, W.; Samardakiewicz, W.; Remlein-Starosta, D. Cross-talk interactions of sucrose and Fusarium oxysporum in the phenylpropanoid pathway and the accumulation and localization of flavonoids in embryo axes of yellow lupine. J. Plant Physiol. 2011, 168, 424–433. [Google Scholar] [CrossRef] [PubMed]
- Morkunas, I.; Ratajczak, L. The role of sugar signaling in plant defense responses against fungal pathogens. Acta Physiol. Plant. 2014, 36, 1607–1619. [Google Scholar] [CrossRef]
- Bolouri Moghaddam, M.R.; Van den Ende, W. Sugars and plant innate immunity. J. Exp. Bot. 2012, 63, 3989–3998. [Google Scholar] [CrossRef]
- Garcí a-Limones, C.; Hervás, A.; Navas-Cortés, J.A.; Jiménez-Díaz, R.M.; Tena, M. Induction of an antioxidant enzyme system and other oxidative stress markers associated with compatible and incompatible interactions between chickpea (Cicer arietinum L.) and Fusarium oxysporum f. sp. ciceris. Physiol. Mol. Plant Pathol. 2002, 61, 325–337. [Google Scholar] [CrossRef]
- Gubanova, L.G.; Kozlenko, L.V. Productivity and grain quality of oats of the steppe ecological group. Proc. Appl. Bot. Genet. Breed. 1985, 93, 79–85. [Google Scholar]
- Stepanova, M.B. The genus Fusarium (Fusarium). In Plant World; Prosveshchenie Publishing House: Moscow, Russia, 1991; Volume 7, 400p. [Google Scholar]
- Zakharenko, V.A. Mycotoxins. In In Plant Protection; 1993; pp. 61–62. [Google Scholar]
- Kononenko, G.P.; Malinovskaya, L.S.; Piryazeva, E.A.; Burkin, A.A.; Soboleva, N.A. Recommendations for mycotoxicological control of fusarium forage grain. Vet. Consult. 2005, 23, 3–10. [Google Scholar]
- Temirbekova, S.K.; Molchan, J.M.; Van Mansvelt, J.D.; Gareev, R.G.; Gotovtseva, I.P.; Musinov, K.M.; Drozdovskaya, A.A. Organic Agriculture: Adaptability, Immunity, Plant Breeding: Rudolf Steiner’s “Course on Agriculture”–80-Year Anniversary; Moscow-Astana: Astana, Kazakhstan, 2005; p. 149. [Google Scholar]
- Radtseva, G.E. Physiological Aspects of the Action of Chemical Plant Growth Regulators; Kolos: Moscow, Russia, 1982; 147p. [Google Scholar]
- Rashid, A. Defense Responses of Plant Cell Wall Non-Catalytic Proteins against Pathogens. Physiol. Mol. Plant Pathol. 2016, 94, 38–46. [Google Scholar] [CrossRef]
- Kumar, S.; Abedin, M.M.; Singh, A.K.; Das, S. Role of Phenolic Compounds in Plant-Defensive Mechanisms. In Plant Phenolics in Sustainable Agriculture; Lone, R., Shuab, R., Kamili, A., Eds.; Springer: Singapore, 2020. [Google Scholar] [CrossRef]
- Osokina, N.V.; Kalashnikova, E.A.; Knyazev, A.N.; Karsunkina, N.P. Influence of cultivation conditions on the characteristics of the development of fungi of the genus Fusarium Triticale in vitro. Izv. Timiryazev Agric. Acad. 2015, 4, 26–35. [Google Scholar]

| No. | Experimental Variants | Bulany (Chaffy) | Naked Oat Line No. 7 | ||
|---|---|---|---|---|---|
| 1000 Kernel Weight, g | Yield, g/m2 | 1000 Kernel Weight, g | Yield, g/m2 | ||
| 1 | Control (untreated) | 40.7 | 350 | 21.1 | 110 |
| 2 | Crezacin | 42.1 | 450 | 20.7 | 135 |
| 3 | Zircon | 40.0 | 440 | 19.8 | 115 |
| 4 | Pathogen (F. culmorum) | 38.9 | 350 | 17.3 | 85 |
| Heading Phase | |||||
| 5 | Zircon + Fusarium | 38.7 | 370 | 23.4 | 130 |
| 6 | Crezacin + Fusarium | 39.2 | 320 | 20.8 | 140 |
| Early Flowering Phase | |||||
| 7 | Zircon + Fusarium | 37.0 | 300 | 21.5 | 100 |
| 8 | Crezacin + Fusarium | 38.0 | 280 | 21.9 | 120 |
| Full Flowering Phase | |||||
| 9 | Zircon + Fusarium | 43.8 | 500 | 22.4 | 170 |
| 10 | Crezacin + Fusarium | 49.3 | 520 | 21.4 | 210 |
| LSD05 | 0.8 | 20 | 0.4 | 11 | |
| No. | Experimental Variants | Presence of F. culmorum in the Grain | |
|---|---|---|---|
| Bulany (Chaffy) Oat | Naked Oat Line No. 7 | ||
| 1 | Control (untreated) | 88.0 | 95.0 |
| 2 | Crezacin | 65.0 | 77.0 |
| 3 | Zircon | 77.0 | 85.0 |
| 4 | Pathogen (F. culmorum) | 90.0 | 97.0 |
| Heading Phase | |||
| 5 | Zircon + Fusarium | 63.79 | 79.0 |
| 6 | Crezacin + Fusarium | 51.69 | 69.0 |
| Early Flowering Phase | |||
| 7 | Zircon + Fusarium | 63.0 | 79.0 |
| 8 | Crezacin + Fusarium | 51.0 | 69.0 |
| Full Flowering Phase | |||
| 9 | Zircon + Fusarium | 45.0 | 55.0 |
| 10 | Crezacin + Fusarium | 30.0 | 41.0 |
| LSD05 | 8 | 10 | |
| Line Number | Protein Content, % | Starch Content, % | Lysine Content, % | Lipid Content, % |
|---|---|---|---|---|
| Line no. 1, Bacha | 14,7 | 57,5 | 7.4 | 8.8 |
| Line no. 4 | 16.5 | 58.1 | 8.5 | 9.9 |
| Line no. 7 | 16.9 | 61.0 | 6,5 | 7,0 |
| Line no. 10 | 18.3 | 63.5 | 8.1 | 8.5 |
| Line no. 13 | 19.7 | 64.0 | 9.4 | 9.0 |
| Var. Ulov (chaffy) | 12.8 | 51.3 | 3.8 | 4.5–5.2 |
Disclaimer/Publisher’s Note: The statements, opinions and data contained in all publications are solely those of the individual author(s) and contributor(s) and not of MDPI and/or the editor(s). MDPI and/or the editor(s) disclaim responsibility for any injury to people or property resulting from any ideas, methods, instructions or products referred to in the content. |
© 2023 by the authors. Licensee MDPI, Basel, Switzerland. This article is an open access article distributed under the terms and conditions of the Creative Commons Attribution (CC BY) license (https://creativecommons.org/licenses/by/4.0/).
Share and Cite
Temirbekova, S.K.; Polivanova, O.B.; Sardarova, I.I.; Bastaubaeva, S.O.; Kalashnikova, E.A.; Begeulov, M.S.; Ashirbekov, M.Z.; Afanasyeva, Y.V.; Zhemchuzhina, N.S.; Ionova, N.E.; et al. Naked Oat and Fusarium culmorum (W.G.Sm.) Sacc. Responses to Growth Regulator Effects. Pathogens 2023, 12, 1051. https://doi.org/10.3390/pathogens12081051
Temirbekova SK, Polivanova OB, Sardarova II, Bastaubaeva SO, Kalashnikova EA, Begeulov MS, Ashirbekov MZ, Afanasyeva YV, Zhemchuzhina NS, Ionova NE, et al. Naked Oat and Fusarium culmorum (W.G.Sm.) Sacc. Responses to Growth Regulator Effects. Pathogens. 2023; 12(8):1051. https://doi.org/10.3390/pathogens12081051
Chicago/Turabian StyleTemirbekova, Sulukhan K., Oksana B. Polivanova, Irina I. Sardarova, Sholpan O. Bastaubaeva, Elena A. Kalashnikova, Marat Sh. Begeulov, Mukhtar Zh. Ashirbekov, Yuliya V. Afanasyeva, Natalya S. Zhemchuzhina, Natalya E. Ionova, and et al. 2023. "Naked Oat and Fusarium culmorum (W.G.Sm.) Sacc. Responses to Growth Regulator Effects" Pathogens 12, no. 8: 1051. https://doi.org/10.3390/pathogens12081051
APA StyleTemirbekova, S. K., Polivanova, O. B., Sardarova, I. I., Bastaubaeva, S. O., Kalashnikova, E. A., Begeulov, M. S., Ashirbekov, M. Z., Afanasyeva, Y. V., Zhemchuzhina, N. S., Ionova, N. E., Statsyuk, N. V., Kirakosyan, R. N., & Saleh, A. (2023). Naked Oat and Fusarium culmorum (W.G.Sm.) Sacc. Responses to Growth Regulator Effects. Pathogens, 12(8), 1051. https://doi.org/10.3390/pathogens12081051









